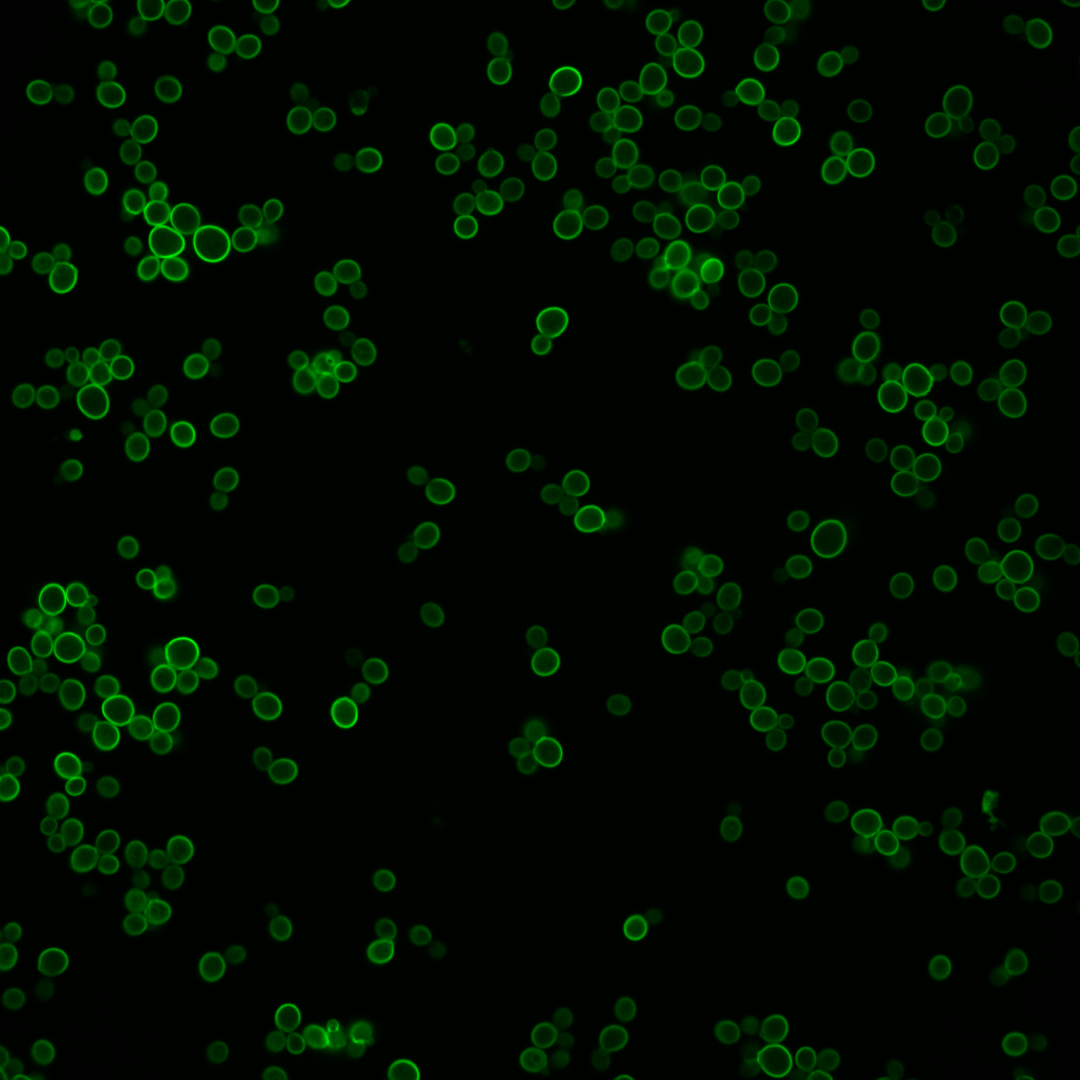
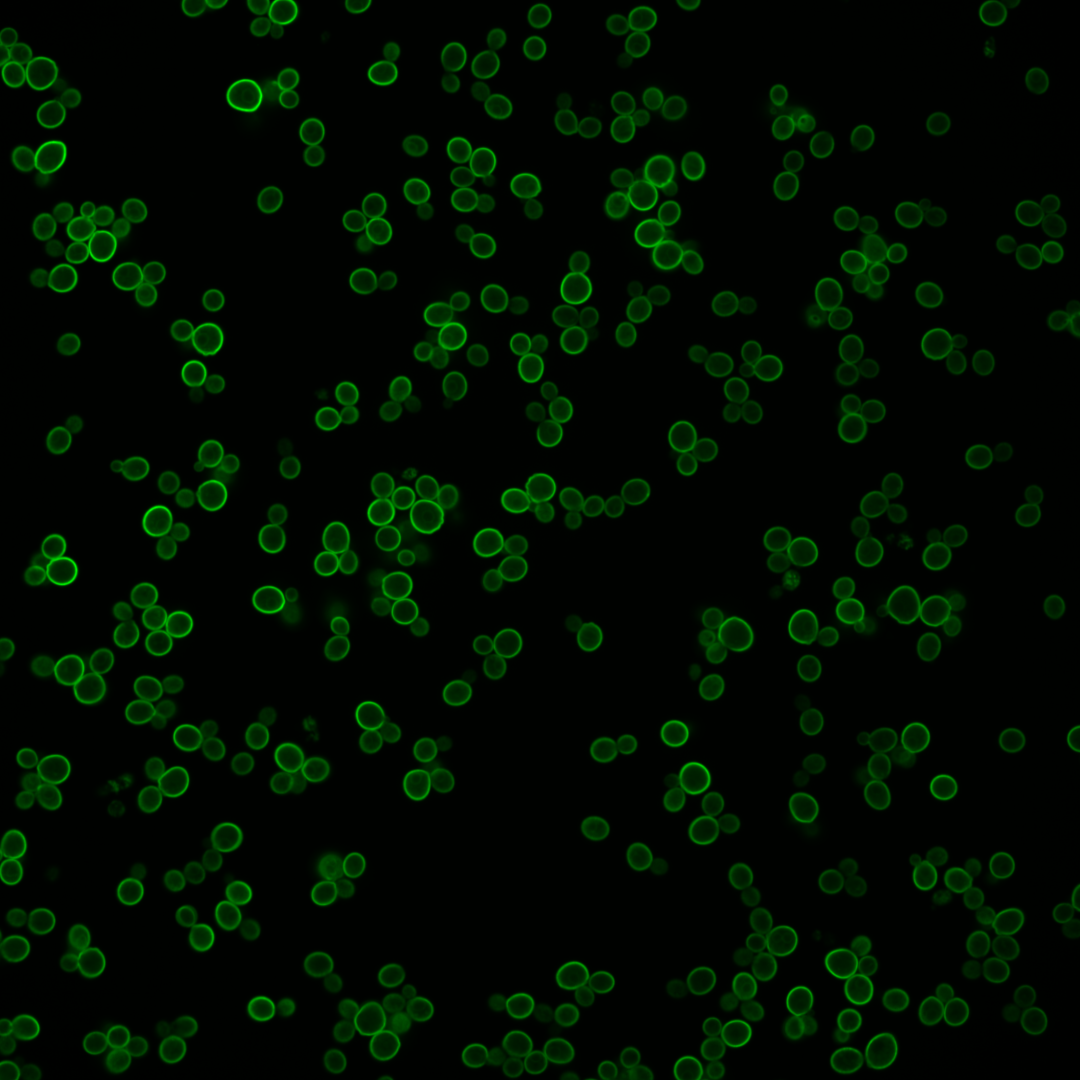
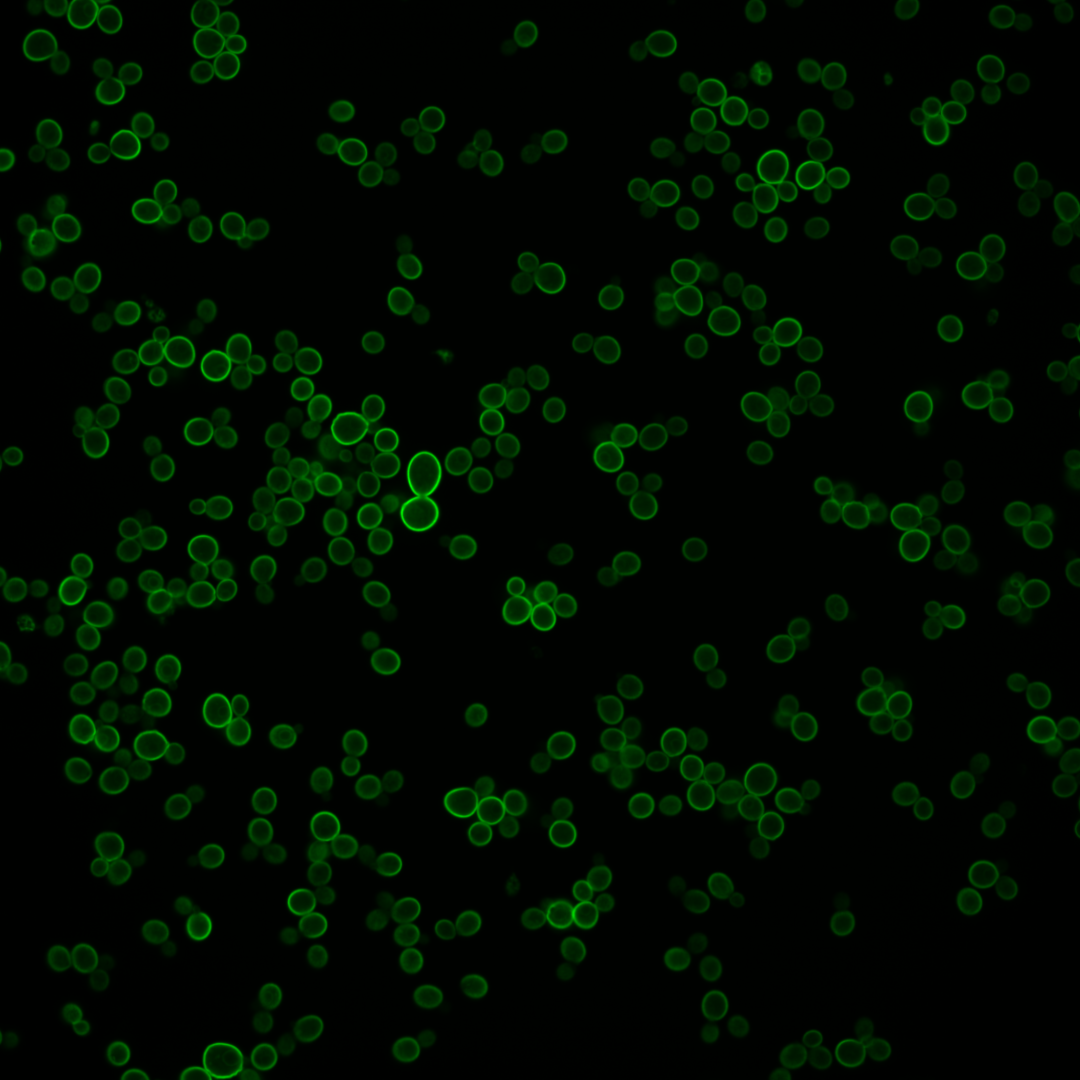
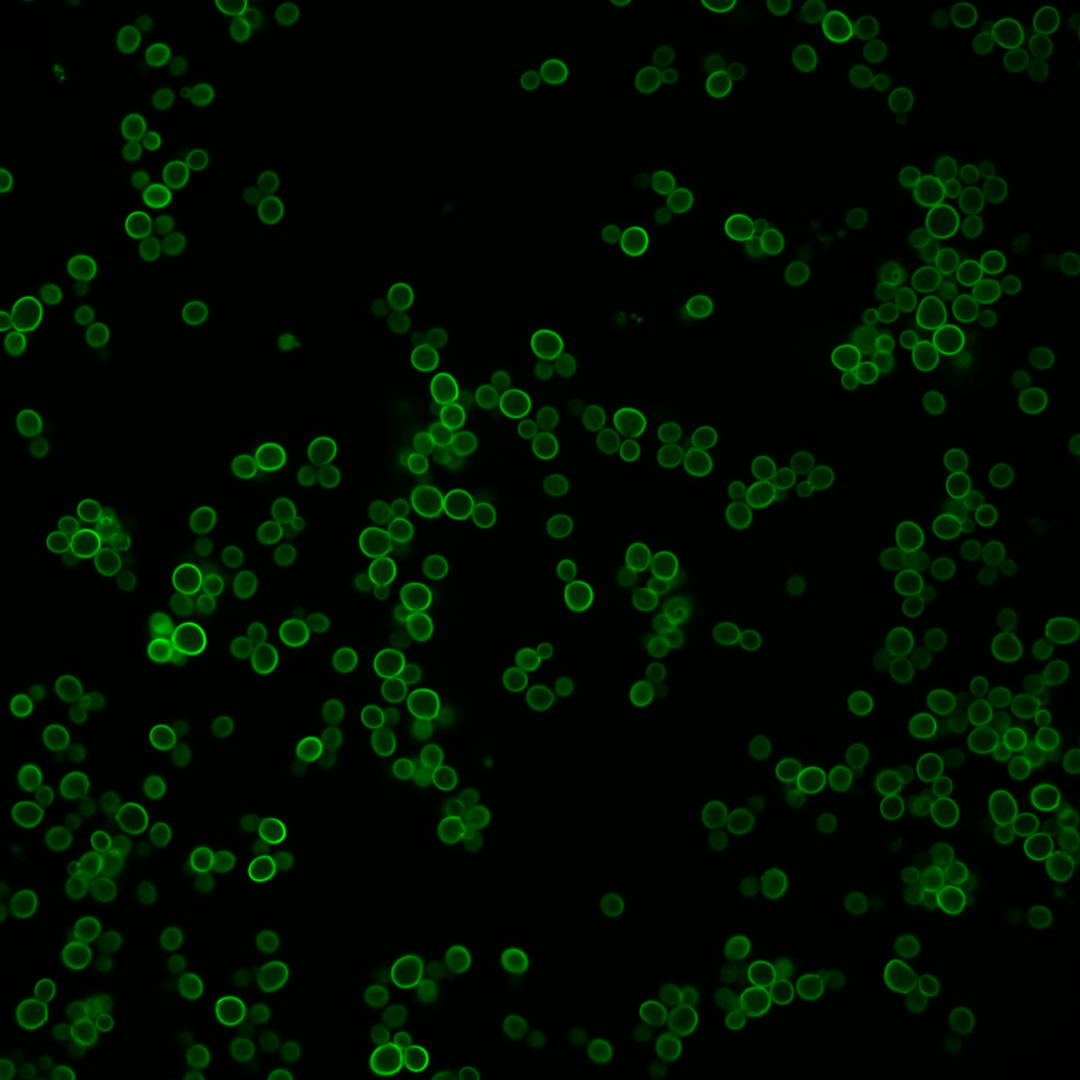

| Standard name | |
|---|---|
| Human Ortholog | |
| Description | Ferro-O2-oxidoreductase; multicopper oxidase that oxidizes ferrous (Fe2+) to ferric iron (Fe3+) for subsequent cellular uptake by transmembrane permease Ftr1p; required for high-affinity iron uptake and involved in mediating resistance to copper ion toxicity, belongs to class of integral membrane multicopper oxidases; protein abundance increases in response to DNA replication stress |
Micrographs




















































































Sub-cellular Localization
Yeast GFP Assignment
Protein Abundance
Localization Change
External localization resources
| ensLOC | DeepLoc | |||||||||||||||||||||||
|---|---|---|---|---|---|---|---|---|---|---|---|---|---|---|---|---|---|---|---|---|---|---|---|---|
| Localization | WT1 | WT2 | WT3 | RAP60 | RAP140 | RAP220 | RAP300 | RAP380 | RAP460 | RAP540 | RAP620 | RAP700 | HU80 | HU120 | HU160 | rpd3Δ_1 | rpd3Δ_2 | rpd3Δ_3 | WT1 | WT2 | WT3 | AF100 | AF140 | AF180 |
| Cortical Patches | 8 | 20 | 15 | 20 | 38 | 86 | 98 | 108 | – | 84 | 114 | 89 | 14 | 4 | 5 | 24 | 6 | 4 | 0 | 2 | 1 | 5 | 5 | 5 |
| Bud | 2 | 8 | 2 | 3 | 5 | 6 | 11 | 13 | – | 9 | 11 | 5 | 0 | 0 | 1 | 9 | 9 | 3 | 0 | 3 | 3 | 5 | 1 | 8 |
| Bud Neck | 0 | 0 | 0 | 0 | 0 | 0 | 0 | 0 | – | 0 | 0 | 0 | 0 | 0 | 0 | 0 | 0 | 0 | 0 | 1 | 0 | 2 | 2 | 2 |
| Bud Site | 0 | 0 | 0 | 0 | 1 | 0 | 0 | 0 | – | 0 | 0 | 0 | 0 | 0 | 0 | 0 | 0 | 0 | – | – | – | – | – | – |
| Cell Periphery | 75 | 199 | 215 | 152 | 154 | 174 | 165 | 180 | – | 156 | 175 | 137 | 458 | 300 | 286 | 339 | 289 | 254 | 87 | 289 | 262 | 287 | 323 | 387 |
| Cytoplasm | 8 | 29 | 7 | 10 | 15 | 21 | 24 | 22 | – | 18 | 32 | 18 | 15 | 13 | 15 | 83 | 45 | 38 | 3 | 18 | 2 | 8 | 4 | 6 |
| Endoplasmic Reticulum | 3 | 8 | 2 | 7 | 15 | 4 | 8 | 22 | – | 11 | 17 | 15 | 39 | 35 | 21 | 13 | 6 | 20 | 11 | 12 | 0 | 40 | 20 | 21 |
| Endosome | 0 | 0 | 0 | 0 | 0 | 0 | 0 | 0 | – | 0 | 0 | 0 | 1 | 1 | 0 | 0 | 0 | 0 | 0 | 0 | 0 | 0 | 0 | 0 |
| Golgi | 0 | 0 | 1 | 0 | 0 | 0 | 0 | 2 | – | 0 | 0 | 0 | 2 | 0 | 0 | 1 | 1 | 1 | 0 | 0 | 0 | 0 | 0 | 0 |
| Mitochondria | 0 | 0 | 0 | 0 | 2 | 13 | 7 | 14 | – | 21 | 32 | 24 | 0 | 0 | 0 | 21 | 13 | 14 | 1 | 8 | 7 | 8 | 5 | 11 |
| Nucleus | 0 | 0 | 0 | 0 | 1 | 0 | 0 | 1 | – | 0 | 0 | 0 | 0 | 0 | 0 | 0 | 1 | 1 | 0 | 0 | 0 | 0 | 0 | 0 |
| Nuclear Periphery | 0 | 0 | 0 | 0 | 0 | 1 | 0 | 6 | – | 0 | 0 | 0 | 0 | 0 | 0 | 0 | 0 | 0 | 0 | 0 | 0 | 0 | 0 | 1 |
| Nucleolus | 0 | 0 | 0 | 1 | 0 | 0 | 0 | 3 | – | 0 | 0 | 0 | 0 | 1 | 0 | 0 | 0 | 0 | 0 | 0 | 0 | 0 | 0 | 0 |
| Peroxisomes | 0 | 0 | 0 | 0 | 2 | 0 | 0 | 0 | – | 0 | 1 | 0 | 0 | 1 | 1 | 0 | 0 | 1 | 0 | 0 | 0 | 0 | 0 | 0 |
| SpindlePole | 0 | 0 | 0 | 0 | 3 | 1 | 4 | 1 | – | 0 | 0 | 0 | 1 | 2 | 1 | 0 | 0 | 0 | 0 | 0 | 0 | 0 | 0 | 0 |
| Vac/Vac Membrane | 0 | 0 | 1 | 0 | 0 | 1 | 0 | 0 | – | 0 | 2 | 0 | 0 | 0 | 1 | 0 | 3 | 0 | 0 | 2 | 0 | 1 | 0 | 0 |
| Unique Cell Count | 82 | 225 | 225 | 170 | 184 | 210 | 203 | 253 | 187 | 230 | 176 | 511 | 348 | 320 | 402 | 330 | 288 | 105 | 341 | 281 | 363 | 366 | 449 | |
| Labelled Cell Count | 96 | 264 | 243 | 193 | 236 | 307 | 317 | 372 | 299 | 384 | 288 | 530 | 357 | 331 | 490 | 373 | 336 | 105 | 341 | 281 | 363 | 366 | 449 | |
Yeast GFP Assignment
Protein Abundance
| Screen | WT1 | WT2 | WT3 | RAP60 | RAP140 | RAP220 | RAP300 | RAP380 | RAP460 | RAP540 | RAP620 | RAP700 | HU80 | HU120 | HU160 | rpd3Δ_1 | rpd3Δ_2 | rpd3Δ_3 | AF100 | AF140 | AF180 |
|---|---|---|---|---|---|---|---|---|---|---|---|---|---|---|---|---|---|---|---|---|---|
| Mean Cell GFP Intensity (1e-4) | 41.1 | 58.3 | 55.3 | 47.7 | 35.2 | 31.0 | 30.4 | 31.9 | – | 32.4 | 31.2 | 31.7 | 75.7 | 79.7 | 81.7 | 41.6 | 52.6 | 59.9 | 39.8 | 41.5 | 46.6 |
| Std Deviation (1e-4) | 9.7 | 15.1 | 12.7 | 12.0 | 12.5 | 11.6 | 11.9 | 10.6 | – | 11.2 | 11.2 | 10.3 | 18.2 | 20.2 | 19.5 | 14.0 | 16.3 | 19.8 | 11.2 | 12.5 | 13.3 |
| Intensity Change (Log2) | – | – | – | -0.21 | -0.65 | -0.84 | -0.86 | -0.79 | – | -0.77 | -0.83 | -0.8 | 0.45 | 0.53 | 0.56 | -0.41 | -0.07 | 0.11 | -0.48 | -0.41 | -0.25 |
Localization Change
| Localization | RAP60 | RAP140 | RAP220 | RAP300 | RAP380 | RAP460 | RAP540 | RAP620 | RAP700 | HU80 | HU120 | HU160 | rpd3Δ_1 | rpd3Δ_2 | rpd3Δ_3 |
|---|---|---|---|---|---|---|---|---|---|---|---|---|---|---|---|
| Cortical Patches | 1.8 | 4.2 | 8.5 | 9.8 | 9.0 | – | 9.0 | 10.2 | 10.0 | -2.5 | -3.6 | -3.1 | -0.3 | -2.9 | -3.1 |
| Bud | 0 | 0 | 0 | 2.7 | 2.7 | – | 0 | 2.5 | 0 | 0 | 0 | 0 | 0 | 0 | 0 |
| Bud Neck | 0 | 0 | 0 | 0 | 0 | – | 0 | 0 | 0 | 0 | 0 | 0 | 0 | 0 | 0 |
| Bud Site | 0 | 0 | 0 | 0 | 0 | – | 0 | 0 | 0 | 0 | 0 | 0 | 0 | 0 | 0 |
| Cell Periphery | -2.4 | -4.0 | -4.3 | -4.7 | -7.0 | – | -4.1 | -5.9 | -5.4 | -2.6 | -3.6 | -2.6 | -4.2 | -3.2 | -3.0 |
| Cytoplasm | 1.3 | 2.2 | 2.9 | 3.5 | 2.6 | – | 2.8 | 4.1 | 2.9 | -0.1 | 0.4 | 0.9 | 6.0 | 4.2 | 4.0 |
| Endoplasmic Reticulum | 0 | 3.7 | 0 | 0 | 3.9 | – | 2.9 | 3.5 | 3.8 | 3.7 | 4.4 | 3.2 | 1.8 | 0 | 3.4 |
| Endosome | 0 | 0 | 0 | 0 | 0 | – | 0 | 0 | 0 | 0 | 0 | 0 | 0 | 0 | 0 |
| Golgi | 0 | 0 | 0 | 0 | 0 | – | 0 | 0 | 0 | 0 | 0 | 0 | 0 | 0 | 0 |
| Mitochondria | 0 | 0 | 3.8 | 0 | 3.6 | – | 5.2 | 5.8 | 5.7 | 0 | 0 | 0 | 3.5 | 3.0 | 3.4 |
| Nucleus | 0 | 0 | 0 | 0 | 0 | – | 0 | 0 | 0 | 0 | 0 | 0 | 0 | 0 | 0 |
| Nuclear Periphery | 0 | 0 | 0 | 0 | 0 | – | 0 | 0 | 0 | 0 | 0 | 0 | 0 | 0 | 0 |
| Nucleolus | 0 | 0 | 0 | 0 | 0 | – | 0 | 0 | 0 | 0 | 0 | 0 | 0 | 0 | 0 |
| Peroxisomes | 0 | 0 | 0 | 0 | 0 | – | 0 | 0 | 0 | 0 | 0 | 0 | 0 | 0 | 0 |
| SpindlePole | 0 | 0 | 0 | 0 | 0 | – | 0 | 0 | 0 | 0 | 0 | 0 | 0 | 0 | 0 |
| Vacuole | 0 | 0 | 0 | 0 | 0 | – | 0 | 0 | 0 | 0 | 0 | 0 | 0 | 0 | 0 |
External localization resources
Images






























Protein Concentration and Protein Localization Data
| R1 | R2 | R3 | ||||||||||||||||
|---|---|---|---|---|---|---|---|---|---|---|---|---|---|---|---|---|---|---|
| G1 Pre-START | G1 Post-START | S/G2 | Metaphase | Anaphase | Telophase | G1 Pre-START | G1 Post-START | S/G2 | Metaphase | Anaphase | Telophase | G1 Pre-START | G1 Post-START | S/G2 | Metaphase | Anaphase | Telophase | |
| Concentration | 58.6619 | 86.2924 | 79.048 | 69.4903 | 68.8493 | 76.483 | 46.2354 | 63.8785 | 56.0166 | 54.0674 | 54.561 | 58.0218 | 91.1106 | 109.6637 | 95.8975 | 95.2188 | 91.9875 | 99.3925 |
| Actin | 0.0155 | 0.0001 | 0.0005 | 0.0032 | 0.0046 | 0.0063 | 0.0426 | 0.0004 | 0.0139 | 0.0214 | 0.0749 | 0.0021 | 0.0006 | 0 | 0.0001 | 0.0001 | 0.0001 | 0.002 |
| Bud | 0.0014 | 0.0001 | 0.0003 | 0.0004 | 0.0009 | 0.0005 | 0.0011 | 0.0001 | 0.0003 | 0.0003 | 0.0001 | 0.0003 | 0.0003 | 0 | 0.0001 | 0.0001 | 0.0001 | 0.0003 |
| Bud Neck | 0.0041 | 0.0003 | 0.0003 | 0.0002 | 0.0024 | 0.0017 | 0.0045 | 0.0003 | 0.0005 | 0.0052 | 0.0007 | 0.0033 | 0.0011 | 0.0002 | 0.0013 | 0.0012 | 0.0026 | 0.0106 |
| Bud Periphery | 0.0036 | 0.0003 | 0.0008 | 0.0007 | 0.0022 | 0.0021 | 0.0054 | 0.0003 | 0.0013 | 0.0007 | 0.0006 | 0.0021 | 0.0016 | 0.0002 | 0.0006 | 0.0011 | 0.0009 | 0.0039 |
| Bud Site | 0.0075 | 0.0005 | 0.0006 | 0.0008 | 0.0022 | 0.0004 | 0.0081 | 0.0017 | 0.0109 | 0.0084 | 0.0003 | 0.0005 | 0.0053 | 0.0004 | 0.0002 | 0.0001 | 0.0001 | 0.0002 |
| Cell Periphery | 0.3769 | 0.5313 | 0.4457 | 0.373 | 0.4074 | 0.4162 | 0.25 | 0.354 | 0.2895 | 0.2393 | 0.2475 | 0.2277 | 0.4736 | 0.6017 | 0.5453 | 0.5563 | 0.4536 | 0.4674 |
| Cytoplasm | 0.0628 | 0.0809 | 0.068 | 0.0154 | 0.0765 | 0.062 | 0.0135 | 0.0212 | 0.0162 | 0.0096 | 0.0014 | 0.0207 | 0.0085 | 0.0158 | 0.0161 | 0.0043 | 0.0732 | 0.0593 |
| Cytoplasmic Foci | 0.0253 | 0.0008 | 0.0038 | 0.0403 | 0.0115 | 0.0028 | 0.0129 | 0 | 0.0031 | 0.0037 | 0.0048 | 0.0023 | 0.0045 | 0 | 0 | 0 | 0 | 0.0001 |
| Eisosomes | 0.0028 | 0.0001 | 0.0003 | 0.0004 | 0.0019 | 0.0039 | 0.0028 | 0.0004 | 0.0012 | 0.0003 | 0.0003 | 0.0005 | 0.0012 | 0.0005 | 0.0004 | 0.0011 | 0.0001 | 0.0005 |
| Endoplasmic Reticulum | 0.2609 | 0.2414 | 0.3266 | 0.3444 | 0.2619 | 0.3163 | 0.5244 | 0.5439 | 0.5852 | 0.6269 | 0.584 | 0.6621 | 0.3038 | 0.1787 | 0.2321 | 0.1702 | 0.2992 | 0.2703 |
| Endosome | 0.0143 | 0.0001 | 0.0008 | 0.0052 | 0.0089 | 0.0114 | 0.0109 | 0 | 0.0006 | 0.0018 | 0.0016 | 0.0006 | 0.0013 | 0 | 0 | 0 | 0 | 0.0001 |
| Golgi | 0.0036 | 0 | 0.0002 | 0.0027 | 0.0019 | 0.0039 | 0.0045 | 0 | 0.0012 | 0.0032 | 0.0038 | 0.0004 | 0.0002 | 0 | 0 | 0.0001 | 0 | 0.0001 |
| Lipid Particles | 0.0237 | 0.0143 | 0.011 | 0.0313 | 0.0124 | 0.0149 | 0.0106 | 0.0053 | 0.0048 | 0.0078 | 0.0051 | 0.0044 | 0.0065 | 0.0054 | 0.0047 | 0.0034 | 0.0042 | 0.0084 |
| Mitochondria | 0.0128 | 0.0001 | 0.014 | 0.0137 | 0.0402 | 0.0144 | 0.007 | 0.0002 | 0.0012 | 0.0008 | 0.0002 | 0.0024 | 0.0003 | 0 | 0 | 0 | 0 | 0 |
| None | 0.0247 | 0.0016 | 0.0016 | 0.0091 | 0.0194 | 0.0014 | 0.0023 | 0.0001 | 0.0049 | 0.0001 | 0.0003 | 0.0027 | 0.0049 | 0 | 0 | 0 | 0 | 0 |
| Nuclear Periphery | 0.0502 | 0.0401 | 0.059 | 0.0468 | 0.039 | 0.0374 | 0.0421 | 0.042 | 0.0359 | 0.0397 | 0.0496 | 0.032 | 0.1012 | 0.1076 | 0.1197 | 0.1532 | 0.0692 | 0.082 |
| Nucleolus | 0.0057 | 0.0003 | 0.0014 | 0.0025 | 0.0039 | 0.0005 | 0.0038 | 0.0005 | 0.0016 | 0.0001 | 0 | 0.0008 | 0.0005 | 0 | 0.0001 | 0.0001 | 0 | 0.0002 |
| Nucleus | 0.0071 | 0.0006 | 0.0011 | 0.002 | 0.0017 | 0.0016 | 0.0115 | 0.0028 | 0.0011 | 0.0003 | 0.0002 | 0.0012 | 0.001 | 0.0003 | 0.0005 | 0.0008 | 0.0008 | 0.0017 |
| Peroxisomes | 0.0027 | 0 | 0.0012 | 0.0034 | 0.0019 | 0.0052 | 0.0071 | 0 | 0.0003 | 0.0069 | 0.0073 | 0.0002 | 0.0001 | 0 | 0 | 0 | 0 | 0 |
| Punctate Nuclear | 0.0073 | 0 | 0.0002 | 0.0132 | 0.0009 | 0.0014 | 0.0041 | 0 | 0.0018 | 0.0002 | 0.0018 | 0.0107 | 0.0011 | 0 | 0 | 0 | 0 | 0.0001 |
| Vacuole | 0.0823 | 0.0872 | 0.0617 | 0.0838 | 0.0967 | 0.094 | 0.0294 | 0.0265 | 0.0243 | 0.023 | 0.0154 | 0.0221 | 0.0818 | 0.0889 | 0.0784 | 0.1068 | 0.0949 | 0.0918 |
| Vacuole Periphery | 0.0047 | 0.0001 | 0.0009 | 0.0076 | 0.0014 | 0.0016 | 0.0015 | 0.0001 | 0.0003 | 0.0002 | 0.0002 | 0.0006 | 0.0007 | 0.0002 | 0.0005 | 0.0011 | 0.0008 | 0.0012 |
Sequencing Data
| R1 | R2 | |||||||||
|---|---|---|---|---|---|---|---|---|---|---|
| G1 Post-START | S/G2 | Metaphase | Anaphase | Telophase | G1 Post-START | S/G2 | Metaphase | Anaphase | Telophase | |
| Gene Expression | 193.1391 | 485.7038 | 711.2511 | 634.2111 | 214.8538 | 362.9813 | 740.5561 | 773.8664 | 758.72 | 742.0451 |
| Translational Efficiency | 0.9441 | 0.9909 | 1.0856 | 0.9534 | 1.0633 | 0.7793 | 0.9315 | 1.025 | 0.9921 | 0.9191 |
Hit Data
| Dataset | Hit |
|---|---|
| Protein Concentration | ✘ |
| Protein Localization | ✘ |
| Gene Expression | ✔ |
| Translational Efficiency | ✘ |
Endocytosis
| Temp | Actin Patch (Sac6-tdTomato) | Cortical Patch (Sla1-GFP) | Late Endosome (Snf7-GFP) | Vacuole (Vph1-GFP) |
|---|---|---|---|---|
| 37℃ | ||||
| RT |
Cell Cycle Omics
CYCLoPs (Fet3-GFP)
| Gene / Allele | Actin Patch (Sac6-tdTomato) | Cortical Patch (Sla1-GFP) | Late Endosome (Snf7-GFP) | Vacuole (Sac6-tdTomato) |
|---|
| Gene | Images |
|---|
| Gene | Images |
|---|
Images are not yet available
Images are not yet available